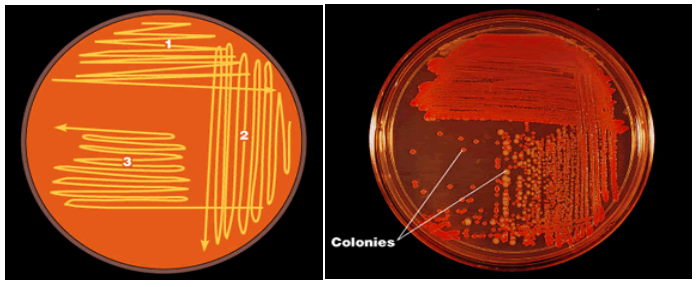
分離純化技術(shù)圖片

微生物分離純化及鑒定技術(shù)
微生物分離純化及鑒定
微生物鑒定是指借助現(xiàn)有的分類系統(tǒng),通過對(duì)未知微生物的特征測(cè)定,對(duì)其進(jìn)行細(xì)菌、酵母菌和霉菌大類的區(qū)分,或?qū)佟⒎N及菌株水平確定的過程,它是藥品微生物檢驗(yàn)中的重要環(huán)節(jié).
非無菌產(chǎn)品的微生物檢查:對(duì)選擇培養(yǎng)基或指示培養(yǎng)基上發(fā)現(xiàn)的疑似菌落需進(jìn)行鑒定;
控制菌檢查(通則1106)
無菌檢查法(通則1101)
對(duì)陽性實(shí)驗(yàn)結(jié)果中分離的微生物進(jìn)行鑒定,以判定試驗(yàn)是否重試;
藥品潔凈實(shí)驗(yàn)室微生物監(jiān)測(cè)和控制指導(dǎo)原則(通則9203),對(duì)潔凈室和其他受控環(huán)境分離到的微生物進(jìn)行鑒定,以掌握環(huán)境微生物污染情況,有助于污染調(diào)查;
其他
對(duì)藥物原料、輔料、制藥用水、生產(chǎn)環(huán)境、中間產(chǎn)物和終產(chǎn)品中檢出的微生物進(jìn)行適當(dāng)水平的鑒定.
微生物鑒定需達(dá)到的水平視情況而定,包括屬、種鑒定和菌株分型
常規(guī)特征分析(屬水平鑒定)
大多數(shù)非無菌藥品生產(chǎn)過程和部分無菌生產(chǎn)環(huán)境的風(fēng)險(xiǎn)評(píng)估中,對(duì)所檢出微生物的常規(guī)特征包括菌落形態(tài)學(xué)、細(xì)胞形態(tài)學(xué)、革蘭染色或其它染色法、及某些能夠給出鑒定結(jié)論的關(guān)鍵生化反應(yīng)進(jìn)行分析.
種水平鑒定
非無菌藥品產(chǎn)品的控制菌檢查應(yīng)達(dá)到種的水平
菌株分型
無菌試驗(yàn)結(jié)果陽性和無菌生產(chǎn)模擬工藝失敗時(shí),對(duì)檢出的微生物鑒定一般需達(dá)到菌株水平.
微生物鑒定程序

分離純化技術(shù)
獲得純培養(yǎng)物對(duì)微生物學(xué)研究至關(guān)重要,平板劃線法是分離純化常用技術(shù).
純培養(yǎng)物是指來源于同一單細(xì)胞的細(xì)胞群體
在劃線過程中,細(xì)胞逐漸分散,培養(yǎng)后可形成單個(gè)菌落.
成功獲得純培養(yǎng)物依賴于樣品中混合在一起的細(xì)胞是否有效的被相互分開.
1、20201
初篩實(shí)驗(yàn)

可能導(dǎo)致染色結(jié)果不理想的原因:
老齡培養(yǎng)物可能導(dǎo)致革蘭氏染色不確定,選用新鮮培養(yǎng)的細(xì)菌;
過度加熱固著可能使革蘭氏陽性菌變?yōu)楦锾m氏陰性菌;
脫色劑使用過多會(huì)出現(xiàn)假陰性,使用太少有可能出現(xiàn)假陽性.
2、芽胞染色21210
細(xì)菌能否形成芽胞以及芽胞的形狀、芽胞在芽胞囊內(nèi)的位置、芽胞囊是否膨大等特征是鑒定細(xì)菌的依據(jù)之一.


20210芽孢染色液
規(guī)格:10ml×4支/盒;包裝內(nèi)容:孔雀綠染色液3支、番紅染色液1支
由于芽孢在結(jié)構(gòu)和化學(xué)成分上均有別于營(yíng)養(yǎng)細(xì)胞,所以芽孢也就具有了許多不同于營(yíng)養(yǎng)細(xì)胞的特性.芽孢是整個(gè)生物界中抗逆性最強(qiáng)的生命體,對(duì)高溫、紫外線、干燥、電離輻射和很多有毒的化學(xué)物質(zhì)都有很強(qiáng)的抗性.
例如,肉毒梭菌的芽胞在沸水中要經(jīng)過5至9.5h才被殺死;巨大芽胞桿菌芽胞的抗輻射能力比E.coli細(xì)胞要強(qiáng)36倍.芽胞的休眠能力更為突出,在常規(guī)條件下,一般可以保持幾年至幾十年而不死.據(jù)文獻(xiàn)記載,有的芽胞甚至可以休眠數(shù)百至數(shù)千年,最極端的例子是在美國(guó)的一塊有2500萬~4000萬年歷史的琥珀,至今從其中蜜蜂腸道內(nèi)還可以分離到有生命的芽胞.
是否能消滅芽孢是衡量各種消毒滅菌手段的最重要的指標(biāo).【50203枯草芽孢桿菌黑色變種芽孢菌片:用于環(huán)氧乙烷滅菌效果檢測(cè);50204嗜熱脂肪桿菌芽孢菌片:用于壓力蒸汽滅菌效果檢測(cè)】芽孢是細(xì)菌的休眠體,在適宜的條件下可以重新轉(zhuǎn)變成為營(yíng)養(yǎng)態(tài)細(xì)胞;產(chǎn)芽孢細(xì)菌的保藏多用其芽孢.(如何獲得芽孢?)產(chǎn)芽孢的細(xì)菌多為桿菌,也有一些球菌.芽孢的有無、形態(tài)、大小和著生位置是細(xì)菌分類和鑒定中的重要指標(biāo).芽孢與營(yíng)養(yǎng)細(xì)胞相比化學(xué)組成存在較大差異,容易在光學(xué)顯微鏡下觀察.
50203枯草芽孢桿菌黑色變種芽孢菌片使用方法:
使用時(shí)將裝有菌片的小紙袋放在被滅菌的物品中心部位(每鍋放置菌片數(shù)按衛(wèi)生部規(guī)定或其它相關(guān)標(biāo)準(zhǔn)規(guī)定).
滅菌后,無菌操作取出小紙袋中的菌片,投放到營(yíng)養(yǎng)肉湯(產(chǎn)品編號(hào)10204,按使用說明配制,分裝試管,5ml/支,滅菌后4℃保存?zhèn)溆?中.同時(shí)將兩片未經(jīng)滅菌的菌片分別投入兩管營(yíng)養(yǎng)肉湯中作對(duì)照.
37℃培養(yǎng)7天,觀察結(jié)果,對(duì)照管呈混濁:若滅菌后營(yíng)養(yǎng)肉湯澄清透明,則為陰性,表示滅菌徹底;若滅菌后營(yíng)養(yǎng)肉湯渾濁,則為陽性,表示滅菌不徹底.
當(dāng)出現(xiàn)陽性結(jié)果時(shí),為確定是否為滅菌后接種操作過程中操作不當(dāng)污染所致,可使用無菌操作取0.2ml營(yíng)養(yǎng)肉湯涂布接種至營(yíng)養(yǎng)瓊脂(產(chǎn)品編號(hào)10103)平板上,置37℃培養(yǎng)48小時(shí),涂片鏡檢或作進(jìn)一步試驗(yàn).
枯草芽孢桿菌為G+桿菌,極易形成芽孢,芽孢位置位于菌體中央,不膨大.芽孢染色為孔雀綠著色.在營(yíng)養(yǎng)瓊脂上菌落呈棕色并隨時(shí)間延長(zhǎng)菌落逐漸著上黑色.
50204嗜熱脂肪桿菌芽孢菌片:
使用時(shí)將裝有菌片的小紙袋放在被滅菌的物品中心部位(每鍋放置菌片數(shù)按衛(wèi)生部規(guī)定或其它相關(guān)標(biāo)準(zhǔn)規(guī)定),視需要也可將小紙袋盛于試管等特定容器中再進(jìn)行滅菌
滅菌后,無菌操作取出小紙袋中的菌片,投放到溴甲酚紫蛋白胨培養(yǎng)液(產(chǎn)品編號(hào)10114,按使用說明配制,分裝試管,5ml/支,滅菌后4℃保存?zhèn)溆?)中.同時(shí)將未經(jīng)滅菌的菌片投入另一管培養(yǎng)液中作對(duì)照.
56℃±1℃培養(yǎng)48小時(shí),觀察結(jié)果,對(duì)照管呈黃色:若滅菌后菌片培養(yǎng)液呈紫色,則陰性,表示滅菌徹底;若滅菌后菌片培養(yǎng)液呈黃色,則為陽性,表示滅菌不徹底.
嗜熱脂肪芽孢桿菌為G+桿菌,芽孢染色為孔雀綠著色.
3、其他染色技術(shù)
抗酸染色;鞭毛染色;內(nèi)含物-異染粒染色

4、需氧類型
接種:用1小環(huán)(外徑1.5毫米的接種環(huán))的肉湯菌液,穿刺接種到培養(yǎng)基中,穿刺到管底.30℃培養(yǎng),分別在3至7天觀察結(jié)果.
結(jié)果觀察:如細(xì)菌在瓊脂柱表面上生長(zhǎng)者為好氧菌,如沿著穿刺線上生長(zhǎng)者為厭氧菌或兼性厭氧菌.

5、生化篩選實(shí)驗(yàn)
1)氧化酶試驗(yàn):(20202)
用于區(qū)分不發(fā)酵的革蘭氏陰性桿菌(氧化酶陽性)和腸道菌(氧化酶陰性)
原理:氧化酶亦即細(xì)胞色素氧化酶,為細(xì)胞色素呼吸酶系統(tǒng)的終末呼吸酶,氧化酶先使細(xì)胞色素C氧化,然后此氧化型細(xì)胞色素C再使對(duì)苯二胺氧化,產(chǎn)生顏色反應(yīng).
操作:暗室中,使用無菌鑷子取出一張紙片,滴加1滴無菌生理鹽水浸濕,挑取新鮮的待
檢菌苔涂抹于紙片上,1分鐘內(nèi)紙片變紫則為陽性.試驗(yàn)副溶血性弧菌為陽性,大腸埃希氏菌為陰性
應(yīng)用:腸桿菌科氧化酶陰性,非發(fā)酵菌氧化酶陽性(個(gè)別除外),弧菌科,奈瑟菌屬、莫拉菌屬陽性.
注:本品見光易變質(zhì),請(qǐng)于暗室保存,使用時(shí)避免遇強(qiáng)光;待檢菌苔必須是新鮮的,且無雜菌,否則極易造成誤判
2)過氧化氫酶試驗(yàn)(20706)
原理:具有過氧化氫酶的細(xì)菌,能催化過氧化氫生成水和原子態(tài)氧,繼而形成分子氧,出現(xiàn)氣泡.
操作:接種環(huán)挑取培養(yǎng)24h菌種一環(huán),涂抹于滴有3%H2O2的玻片上.

應(yīng)用:革蘭氏陽性球菌中,葡萄球菌和微球菌均產(chǎn)生過氧化氫酶,而鏈球菌屬為陰性,故此試驗(yàn)常用于革蘭陽性球菌的初步分群.
3)凝固酶試驗(yàn)
凝固酶:致病性葡萄球菌大多能產(chǎn)生凝固酶,非致病葡萄球菌不產(chǎn)生此酶.凝固酶分為結(jié)合型和游離型兩種.
結(jié)合型凝固酶:結(jié)合在細(xì)胞壁,與纖維蛋白原結(jié)合,使纖維蛋白原變?yōu)槔w維蛋白,引起細(xì)菌凝集,采用玻片法檢測(cè);
游離型凝固酶:分泌至細(xì)菌體外,被血漿中凝固酶反應(yīng)因子激活,形成葡萄球菌凝血酶,使纖維蛋白原變?yōu)槔w維蛋白,導(dǎo)致血漿凝固,采用試管法檢測(cè).
操作:
玻片法——取潔凈玻片一張,滴加兔血漿(20802)一滴;用接種環(huán)取實(shí)驗(yàn)菌苔一環(huán),在兔血漿中研磨混勻;結(jié)果觀察:如出現(xiàn)顆粒狀凝集現(xiàn)象即為血漿凝固酶實(shí)驗(yàn)陽性.如不立即發(fā)生凝集,可輕搖玻片加速反應(yīng),若仍無凝集則為陰性.

試管法——取肉湯培養(yǎng)物0.5ml同0.5ml兔血漿于試管內(nèi)充分混合,置36±1℃培養(yǎng);定時(shí)觀察是否有凝塊形成,至少觀察6h,以內(nèi)容物完全凝固,使試管倒置或傾斜時(shí)不流動(dòng)者為陽性.
陽性對(duì)照:金黃色葡萄球菌兔血漿&凍干兔血漿
4)碳水化合物氧化和發(fā)酵
不同微生物分解利用糖類的能力有很大差異,或能利用或不能利用,能利用者,或產(chǎn)氣或不產(chǎn)氣.可用指示劑及發(fā)酵管檢驗(yàn).
實(shí)驗(yàn)方法:
以無菌操作,用接種針或環(huán)移取純培養(yǎng)物少許,接種于發(fā)酵液體培養(yǎng)基管,若為半固體培養(yǎng)基,則用接種針作穿刺接種.
接種后,置36±1℃培養(yǎng),每天觀察結(jié)果,檢視培養(yǎng)基顏色有無改變(產(chǎn)酸),小倒管中有無氣泡,微小氣泡亦為產(chǎn)氣陽性,若為半固體培養(yǎng)基,則檢視沿穿刺線和管壁及管底有無微小氣泡,有時(shí)還可看出接種菌有無動(dòng)力,若有動(dòng)力、培養(yǎng)物可呈彌散生長(zhǎng).

北京天優(yōu)福康生物科技有限公司
官網(wǎng):http://www.gzs9.cn/
服務(wù)熱線:400-860-6160
聯(lián)系電話/微信:13718308763
QQ:2136615612 3317607072
E-mail:Tianyoubzwz@163.com



